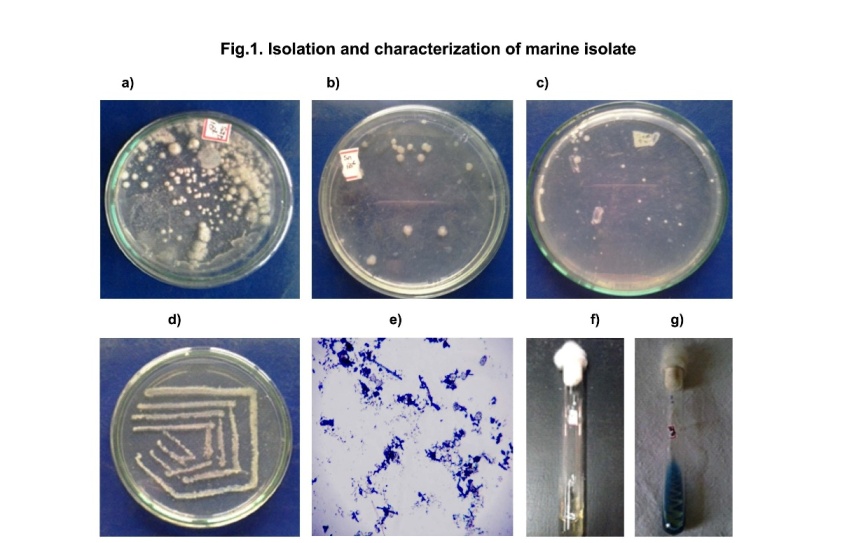

Int J Pharm Pharm Sci, Vol 8, Issue 8, 277-284Original Article
ANTIOXIDANT AND ANTIPROLIFERATIVE POTENTIALS OF MARINE ACTINOMYCETES
NAGASESHU P.*, GAYATRIDEVI V., ANIL KUMAR B., SEEMA KUMARI, MURALI MOHAN G., RAMA RAO MALLA
aCancer Biology Lab, Department of Biochemistry, GITAM University, Visakhapatnam, Andhra Pradesh, India 530045, bDepartment of Chemistry, GITAM University, Visakhapatnam, Andhra Pradesh, India 530045
Email: dr.rrmall@gmail.com
Received: 28 Apr 2016 Revised and Accepted: 20 June 2016
ABSTRACT
Objective: The aim of present studyis to isolate and characterize a novel actinomycetes strain from marine sediments collected at Kakinada coast. To evaluate antioxidant and antiproliferative activities of the crude methanolic extract of isolated actinomycetes.
Methods: Actinomycetes was isolated from marine sediments collected at Kakinada coast using starch casein agar. Morphological, biochemical and molecular characterization was performed and the crude methanolic extract was used for determination of in vitro antioxidant activity and antiproliferative activity against MDA-MB 231 breast cancer cells.
Results: The crude methanolic extract exhibited significant antioxidant activity with IC50 value in the range of 30-46 µg/ml in different radical scavenging assays. Moreover, the extract showed concentration dependent cytotoxicity against triple negative breast cancer cell line, MDA-MB 231 with IC50 of 42.5µg/ml. The extract also inhibited cell proliferation with IC50 value 44.1 µg/ml probably by arresting cell cycle at S phase. The antioxidant activity of the extract was strongly correlated with cytotoxic and antiproliferative activity.
Conclusion: The isolated marine actinomycetes can be the potential source of antioxidants with the anticancer property.
Keywords: Marine actinomycetes, Antioxidant, Antiproliferative, MDA-MB 231
© 2016 The Authors. Published by Innovare Academic Sciences Pvt Ltd. This is an open access article under the CC BY license (http://creativecommons.org/licenses/by/4.0/)
INTRODUCTION
Oxidative stress produces reactive oxygen species (ROS) as a body’s natural chemical process. Super oxide anions (O2.-), hydroxyl radicals (. OH), singlet oxygen and hydrogen peroxide (H2O2) are highly unstable and damage free radical cells. High levels of free radicals involve in signaling mechanisms and development of Alzheimer’s, eye, heart and Parkinson’s disease and cancer. Studies over centuries demonstrated that antioxidants encounter oxidative stress and prevent stress associated diseases [1].
Humans have the complex network of the antioxidant system consisting of enzymatic antioxidants such as superoxide dismutase, catalase and non-enzymatic antioxidants such as reduced glutathione, ascorbic acid, α-tocopherol, β-carotene and flavonoids to counteract reactive oxygen species [2]. Dietary antioxidants such as flavonoids and alkaloids also play a significant role in augmenting the body’s natural resistance to oxidative stress [3].
Antioxidants interfere with oxidative stress by reacting with free radicals, chelating metals and scavenging oxygen in biological systems [4]. The supplementation of antioxidants neutralize the effect of free radicals in the body and prevent the incidence of many diseases [5]. Antioxidants also have health benefits as antiaging and anticancer agents [6]. Now-a-days studies on antioxidants have become a major subject of extensive research due to the ever-increasing demand in food and pharmaceutical industries. Previously, antioxidants have been reported in an animal, plant and microbial sources. Actinomycetes produce chemically diverse metabolites with a broad spectrum of biological activities including antibacterial, antifungal, anticancer and insecticidal activities. Actinomycetes are filamentous gram-positive bacteria and represent one of the most efficient producers of secondary metabolites. The vast structural diversity of actinomycetes serves as a source of novel therapeutics with safety, efficacy, sensitivity and target specificity.
The investigation on identification and isolation of biologically active marine actinomycetes was begun across the world, since 1960 [7]. Forty of floristic inventory of marine actinobacteria in Indian peninsula yielded 41 species belonging to 8 genera. The majority of the studies have been conducted on the actinomycetes isolates from sediments in the coastal areas of Maharastra, Kerala, Tamil Nadu and Andhra Pradesh.
In 1974, Sambamurthy and Ellaiah have been reported antagonistic Streptomyces species from the Visakhapatnam coast [8]. Subsequently, Ellaiah and Reddy isolated 140 strains of actinobacteria with antibacterial activity from marine sediments of Visakhapatnam coast and identified them up to genus level [9]. In the year 1996, Ellaiah et al., isolated actinobacteria from sediments of the Bay of Bengal and the strains with antagonistic activity were identified up to species level [10]. Ellaiah et al., isolated 80 strains of actinobacteria with antibacterial and proteolytic activity from Machilipatnam coast by plating on starch casein agar media [11]. In the year 2004, Ellaiah et al.,have isolated 60 actinobacteria with antibacterial and antifungal activity from the Bay of Bengal near Kakinada coast using starch casein agar medium [12].
Actinomycetes producing cytotoxic agents was isolated from marine sediments of the Bay of Bengal, India [13]. Actinobacteria with antimicrobial and cytotoxic activities have been isolated from off shore sediments of the Bay of Bengal, India [14] Tetracenomycin D and quinone-related compounds with antitumor activity have been isolated from different actinomycetes collected from the Bay of Bengal, India. Bioactive substances inhibiting leukemia cell growth have been purified from a salt-tolerant marine Actinobacterium species [15]. A total of 50 actinomycetes strains with cytotoxicity were isolated from the Puducherry coast [16]. Ravi kumar et al., demonstrated the antiproliferative property of marine actinomycetes against different breast cancer cell lines [17]. In the present study, actinomycetes with antioxidant activity and the antiproliferative activity against MDA-MB 231 cells was isolated and characterized from the sediments of Kakinada coast, Andhra Pradesh by plating on starch casein agar media.
MATERIALS AND METHODS
Cell line
MDA-MB 231 cell line was obtained from the National Center for Cell Science, Pune, India. The cells were grown to 70% confluence in DMEM supplemented with 10% FBS, L-glutamine (2 mM), penicillin–streptomycin (100µg/ml) (Sigma, USA) in a humid atmosphere of 5% CO2 at 37 °C.
Instruments/apparatus
Spectrophotometer (Biodrop), CO2 incubator (New Brunswick), inverted fluorescent microscope (Lynx), PCR (Eppendorf), electrophoretic apparatus (Major sciences), ELISA reader (Bio-Rad), Flow cytometry (BD sciences).
Collection of marine sediments
Nineteen sediments were collected into sterile Zip lock polythene bags from different locations of Andhra Pradesh coast of Bay of Bengal, India in a depth of 30-200 meters using grab sampler (table 1). The marine sediments were air dried for preventing bacterial contamination. The sediment samples were prepared by adding 1g of sediment to 10 ml of 50% sea water in distilled water and serially diluted to till 10-7dilution.
Isolation of actinomycetes isolates
The sample (0.1 ml) was spread uniformly over starch casein agar, chitin agar and glycerol asparagine agar containing fluconazole (75µg/ml) and rifampicin (10µg/ml) and incubated at 28oC for three weeks. The colonies with actinomycetes morphology from sediment samples, S1-S7 were marked and scored out. The pure isolate was obtained from S7 by repeated streaking on starch casein agar. The purified isolate was preserved as slant culture in starch casein agar medium and as a glycerol stock in 20% glycerol.
Morphological characterization
The purified isolate was identified up to genus level based on morphological characteristics. The selected strain was streaked on starch casein agar media, incubated for 1 w at 28oC and macro morphological features were observed [18]. Direct and inclined cover slip methods were used to determine micromorphological characteristics such as aerial mycelium and sporulation. In direct method, 100 µl of the purified isolate was streaked four to five times with equal space on starch casein agar plate. A smear of the isolate was prepared on the glass slide and observed under bright field microscope on a 12th day of incubation. Aerial mycelium and spore chain morphology was recorded. In inclined cover slip method, a sterile cover slips were placed at an angle of 45o into solidified starch casein agar medium such that half of the cover slip was placed in the medium. The isolate was spread along the line where the upper surface of the cover slip meets the medium. The petri plates were incubated at 28o C for 12 d. Spores were examined under the microscope at different magnifications [19].
Gram’s staining
A smear of the isolate was prepared on to the clear glass slide, allowed to air dry and heat fixed. The heat fixed smear was flooded with crystal violet and washed with water. Then flooded with mordant, Gram’s iodine for 1 min and decolorized with 95% ethyl alcohol. After washing, the smear was counter stained with safranin for 45 sec. After washing with water, smear was blotted with tissue paper and examined under the microscope at 100x magnification using oil immersion.
Biochemical characterization
Pure isolated was subjected to biochemical tests such as hydrolysis of gelatin, starch, casein and citrate, Methyl Red, Voges Proskauer, urease, catalase, amylase and H2S production according to Bergey’s manual and Lampert [20].
Molecular characterization
Isolate was aseptically inoculated into starch casein broth medium, incubated in a rotary shaker set at 180 rpm for 2 d at 30ºC and then centrifuged at 10,000 rpm for 10 min. The pellet was suspended in TE buffer and total genomic DNA was extracted using a modified cetyltrimethylammonium bromide-NaCl. 16S rRNA was amplified from the extracted genomic DNA using the universal eubacteria 16S rRNA gene primers: 5’-AGAGTTTGATCH YGGYTYAG-3’(F) and 5’-ACGGCTACCTTGTTACGACTT-3 (R) where =A or C or T; Y=C or T. The amplified product was sequenced on ABI 3730xl Sequencer by Sanger’s method using internal primers specific for whole 16S region. The 16S rRNA sequence was compared and aligned with sequences deposited in the NCBI-GenBank database using BLAST for identification of actinomycetes. Phylogenetic analysis of isolate was used for the construction of the phylogenetic tree. The 16S rRNA gene sequences of isolate was submitted to NCBI-GenBank under accession number, KU375127.
Preparation of the crude methanolic extract
The pure actinomycetes isolate was grown in the medium containing 4 g/l of glucose, 10 g/l of malt extract and 4 g/l of yeast extract in 50% sea water for 10 d under continuous shaking (100 rpm). Then pH of the medium was adjusted to 5.0 with 1N hydrochloric acid, equal volume (1:1) of methanol was added, and mixed by vigorous shaking and kept without disturbance. The organic phase was collected and evaporated at 70oC in an incubator. Different concentrations (20-100µg/ml) of the crude methanolic extract in 5% DMSO was prepared and used for determination of antioxidant and antiproliferative activity.
DPPH radical scavenging activity
The DPPH radical scavenging activity of the crude methanolic extract was measured according to the procedure described by Rama Rao et al., (2008) [21]. This method is based on the reduction of alcoholic DPPH solution (dark blue in colour) in the presence of a hydrogen donating antioxidant. The solution was incubated at 37oC for 30 min and the optical density was measured at 517 nm using spectrophotometer (Biodrop). BHT was taken as standard (20-100µg/ml). The percent of DPPH radical scavenging activity was calculated using the formula. Percent of radical scavenging activity: A 517 (control)-A517 (test)/A 517 (control) x 100.
Hydroxyl radical scavenging activity
Deoxyribose assay used to determine the hydroxyl radical scavenging activity of the crude methanolic extract [22]. 100 µl of the crude extract, 100 µl of hydrogen peroxide and 800 µl of phosphate buffer pH 7.4 was added to the reaction mixture containing each of 500 µl deoxy ribose, ferric chloride, EDTA, ascorbic acid and incubated for 1h at 37oC. The mixture was heated at 100oC in the water bath for 20 min. After cooling on ice, 1 ml each of TCA (2.8%) and TBA (1%) was added, and centrifuged at 4000 rpm for 15 min and optical density was measured at 532 nm using spectrophotometer (Biodrop). BHT was taken as standard (20-100µg/ml). Percent of hydroxyl radical scavenging activity: A 532 (control)-A532 (test)/A 532 (control) x 100.
Super oxide radical scavenging activity
The measurement of superoxide scavenging activity of the crude extract was carried out based on method as described by Liu et al., (1997) [23]. 100 µl of the crude extract was added to the reaction mixture containing 1 ml of sodium carbonate, 0.4 ml of NBT, 0.2 ml of EDTA, 0.4 ml of hydroxyl amine hydro chloride. The reaction mixture was incubated at room temperature for 5 min and the optical density was measured at 560 nm using spectrophotometer (Bio drop). BHT was taken as standard (20-100µg/ml). The percent of inhibition was calculated by the formula: A 560 (control)-A560 (test)/A 560 (control) x 100.
FRAP assay
To determine the ferric ion reducing ability of the crude extract, FRAP assay was used [24]. This method was based on the reduction of ferric tripyridyltriazine (Fe3+-TPTZ) complex to the intensely blue coloured Fe2+complex Fe (TPTZ)2+by the crude extract in acidic medium (pH 3.6). To 1.5 ml of FRAP reagent [2.5 ml of 0.3M acetate buffer, pH 3.6, 0.25 ml of 10 mM 2,4,6-tripyridyl-s-triazine (TPTZ) solution and 0.25 ml of 20 mM ferric chloride], 1.0 ml of the crude extract was added and absorbance was measured at 595 nm. Blank was set up with 1.5 ml of FRAP reagent and 1.0 ml of methanol and proceeds as per the test. The calibration curve was prepared using FeSO4 with the concentration ranging from 0-500 mM. The results are expressed as Ascorbic acid Equivalent Antioxidant capacity in terms of (AEAC).
MTT assay
MTT assay used to evaluate the cytotoxic effect of the crude methanolic extract on MDA-MB-231 cells. Monolayer cells in 96-well plate (5x103/well) were treated with the crude methanolic extract for 48h. Cells treated with methanol and maintained under similar conditions was served as control. After treatment, MTT reagent (5 mg/ml of PBS) added to each well, incubated for 2h and DMSO added to solubilize formazan crystals. Absorbance at 595 nm was measured using ELISA plate reader. The percent reduction of cell viability expressed by comparing with methanol treated cells, which set as 100%.
Sulphorhodamine B (SRB) assay
SRB assay used to evaluate the effect of the crude methanolic extract (20-100µg/ml) on a survival of MDA-MB-231 cells [25]. Monolayer cells in the 96-well plate (5x103/well) were treated with the crude methanolic extract for 48h. The cells treated with methanol and maintained under similar conditions was served as control. After 48h incubation, adherent cell cultures were fixed in situ by adding 50μl of cold 40% (w/v) trichloroacetic acid and incubated for 60 min at 4 °C. After discarding the supernatant, the cells were washed with deionized water. To each well, 50μl of SRB solution (0.4% w/v in 1% acetic acid) was added and incubated for 30 min at room temperature. Unbound SRB was removed by washing with 1% acetic acid. Then, the plate was air-dried and 100μl of 10 mM Tris base pH 10.5 (Sigma) was added to each well to solubilize the dye. The plate was shaken gently for 20 min on a plate shaker and the absorbance was read using the ELISA reader at 570 nm. Cell survival was calculated as the percent absorbance compared to that of the untreated control.
BrdU incorporation assay
BrdU incorporation assay used to determine effect of the crude methanolic extract on cell proliferation [26]. Cells (10x103/well) were seeded in triplicate into 96-well plates and allowed to grow overnight before treatment with the crude methanolic extract for 48h. After treatment, cells were labeled with diluted BrdU (1:2000) for12h. The cells were fixed and incubated for 30 min at room temperature. After incubation, anti-BrdU antibody (1:100) added and incubated for 1h. After washing, conjugate antibody (1:2000) was added and incubated for 30 min. After washing, tetra-methylbenzidine substrate added and incubated in dark for 15 min. Then stop solution was added and absorbance was read at the dual wavelength of 450 and 540 nm with in 30 min.
Cell cycle analysis
MDA-MB 231 cells were harvested at 12, 24 and 48h after treating with the crude methanolic extract at concentration of 60 μg/ml and fixed with ice-cold 70% ethanol at 4 °C overnight. Then fixed cells were washed thrice with PBS and stained with 50 μg/ml propidium iodide in the presence of RNase A (10 μg/ml). Cells in different phases of the cell cycle were analyzed by flow cytometry.
Cell morphology by phase contrast microscopy
Cells were left untreated or treated with the crude methanolic extract at 60μg/ml for 48 h. The media were removed and washed three times with PBS. The cell images were captured under the phase contrast inverted microscope.
Statistical analysis
Statistical analysis and graphical exploration of the data were done using Pearson correlation coefficient calculator. R-value was calculated using an algorithm supplied by the meta-numerics statistical library. IC50 value was calculated using the regression analysis (micro soft excel 2010). All the experiments were carried out three times. Values are shown as means±SD of at least three independent experiments. Significance set as p<0.001.
RESULTS AND DISCUSSION
Screening and the characterization of actinomycetes
Actinomycetes are ubiquitous marine organisms. East coast of the Bay of Bengal, Andhra Pradesh, India especially from Visakhapatnam to Thamarapatnam have the wide range of salinities and was selected for isolation of diverse actinomycetes with antioxidant and anticancer activity. Primary isolation of actinomycetes was based on source, selective media, and culture conditions. A total 80 actinomycetes isolates were obtained from 19 sediments collected from different locations of East Coast Bay of Bengal, Andhra Pradesh in a depth of 30-200 m using starch casein agar, chitin agar and glycerol asparagine agar plates (table 1). The isolates collected from Visakhapatnam region was designated as S1, S2 and S3; Kakinada as S4, S5, S6 and S7; Divipoint as S8, S9, S10 and S11; Singarayakonda as S12, S13, S14 and S15; Thamerapatnam as S16, S17, S18 and S19. The isolates obtained from Kakinada region using starch casein agar (S4, S5, S6 and S7) exhibited characteristic morphology of actinomycetes such as leathery and powdery colonies (fig. 1a) compared to other media used (fig. 1b and c). Among the media used, starch casein agar prepared with 50% sea water supported the growth and resulted in isolation of more number of actinomycetes isolates even at 10-7 dilution. The results of present study are in agreement with the findings of Sirisha et al., (2013) [27]. Among the four isolates (S4-S7), pure isolate with characteristics of actinomycetes was obtained from S7 by repeated streaking on starch casein agar (fig. 1d). Previous studies reported that isolation of marine actinomycetes require sea water for their growth [28]. Earlier workers reported that actinomycetes grow on starch casein agar [29].
Table 1: Locations and transects of the sediment samples collected from East coast of the bay of bengal, Andhra Pradesh
| S. No. | Date | Latitude | Longitude | Depth (m) | Location |
1 2 3 |
1.09.2009 1.09.2009 1.09.2009 |
17 °50.814N 17 °50.556N 17 °51.264N |
84 °01.422E 83 °01.228E 83 °32.060E |
265.00 52.93 29.64 |
Visakhapatnam |
4 5 6 7 |
2.09.2009 2.09.2009 2.09.2009 2.09.2009 |
16 °59.832N 16 °59.507N 16 °59.805N 16 °49.885N |
82 °58.065E 82 °43.923E 82 °32.497E 82 °25.665E |
201.17 108.05 50.87 34.61 |
Kakinada |
8 9 10 11 |
3.09.2009 3.09.2009 3.09.2009 3.09.2009 |
15 °59.813N 15 °59.813N 15 °59.481N 15 °59.943N |
81 °29.045E 81 °24.737E 81 °22.716E 81 °20.229E |
191.00 88.11 62.72 31.28 |
Divipoint |
12 13 |
4.09.2009 4.09.2009 |
15 °00.551N 15 °00.140N |
80 °24.985E 80 °20.764E |
192.60 106.26 |
Singarayakonda |
14 15 |
4.09.2009 4.09.2009 |
15 °00.199N 15 °00.296N |
80 °16.943E 80 °12.826E |
56.19 34.40 |
|
16 17 18 19 |
5.09.2009 5.09.2009 5.09.2009 5.09.2009 |
14 °00.276N 14 °00.106N 14 °00.119N 14 °00.219N |
80 °26.946E 80 °24.532E 80 °21.586E 80 °20.747E |
242.00 104.00 46.53 37.37 |
Thamerapatnam |
Location of actinomyctes sample collected from the East Coast of the Bay of Bengal
Fig. 1: Isolation and characterization of marine isolate, Serially diluted sediment sample was spread over starch casein agar (a), chitin agar (b) and glycerol asparagine agar (c) containing fluconazole and rifampicin and incubated at 28oC. (d)The pure isolate was obtained from S7 by repeated streaking on starch casein agar. (e) Identification of marine isolate by Gram’s staining. Biochemical characterization of marine isolate using gelatin hydrolysis (f) and citrate utilization (g) The values were expressed as n=3
A well-defined biodiversity and taxonomic study of actinomycetes is important to understand actinomycetes from the marine environment. The morphological criteria such as characteristics of colonies on the plate, the morphology of substrate mycelium and aerial hyphae, the morphology of spores and pigments produced are used for preliminary identification of Actinomycetes. It can be distinguished from true bacteria, which shows fast growth and slimy distinct colonies. However, actinomycetes shows slow growth and powdery consistency and stick to agar surface.
The results of cultural characteristics show that the colony of isolate, S7 are slow growing, chalky with aerial and substrate mycelia of different colors. In addition, the isolate was gram positive and also exhibited an earthy order (fig. 1e). Biochemical tests such as hydrolysis of gelatin, starch, casein and citrate, Methyl Red, Voges Proskauer, urease, catalase, amylase and H2S production were used identity isolate (table 2). The isolate showed positive results in gelatin and citrate hydrolysis (fig. 1f and g) and negative results in casein, Methyl Red, Voges Proskauer, urease, catalase and H2S production tests. The isolate was identified up to the generic level as actinomycetes based on the colony morphology and microscopic morphology. The isolate exhibited cream color aerial mycelia and light yellow color spore mass, yellow color vegetative mycelia and cream colored soluble pigment (table 3). Siva Kumar (2007) reported that these characteristics can be used as a marker for recognition of individual actinomycetes strains [30].
Table 2: Biochemical characteristics of marine isolate
| S. No. | Name of the test | Inference/response |
| 1 | Gelatin hydrolysis | Positive |
| 2 | Starch hydrolysis | Positive |
| 3 | Casein hydrolysis | Negative |
| 4 | Citrate utilization test | Positive |
| 5 | Catalase test | Negative |
| 6 | Methyl red test | Negative |
| 7 | Urease test | Negative |
| 8 | H2 S production test | Negative |
| 9 | Amylase test | Negative |
| 10 | voges prokeurs test | Negative |
Table 3: Morphological characteristics of marine isolate
| S. No. | Sediments | Number of isolates | Aerial hyphae | Color of vegetative mycelia | Growth | Spore mass colour | Soluble pigment |
| 1 | S4 | 2 | Brown | Green | Good | Brown | Brown |
| 2 | S5 | 2 | Yellow | Brown | Good | Blue | Green |
| 3 | S6 | 2 | Grey | White | Good | Grey | Grey |
| 4 | S7 | 2 | Creamy | Yellow | Abundant | Light yellow | Creamy |
The sequence of the 16S rRNA gene has been widely used to evaluate relationships between actinomycetes (phylogeny). Recently, 16S rRNA gene sequence also used to identify an unknown actinomycetes up to the genus or species level. The identification of phylogenetic neighbors and the calculation of pair wise 16S rRNA sequence similarities were achieved. In addition, the sequences was compared to the sequences with the NCBI database using BLAST algorithm. Sequences were aligned and a phylogenetic tree was constructed. 16S rRNA sequence were deposited in GenBank under accession number KU375127. 16S rRNA gene sequence analysis revealed that the isolated strain was a member of order acidomicrobials. The 16S rRNA gene sequence showed 90% similarity with acidoterrimonas ferrireducens (fig. 2a and b).

Fig. 2: Identification of phylogenic neighbors and pairwise sequencing, (a) Neighbor-joining phylogenetic tree from analysis of 16S rRNA gene sequence of marine isolate. The numbers are the percentages indicating the levels of boot strap support, based on a neighbor-joining analysis of 939 resampled data sets. The scale bar represents 0.01 substitutions per nucleotide position. (b) Identification of marine isolate by BLAST analysis. The result shows the percentage of coverage and identification
Antioxidant activity
Generation of free radicals related with oxidation of molecules in various biological systems. Hence, determination of antioxidant activity by one method cannot identify all possible mechanisms. Therefore, different free radical scavenging methods was used to evaluate antioxidant activity of the crude methanolic extract [31].
DPPH is stable 2, 2-diphenyl-1-picrylhydrazyl radical. It is widely used to monitor chemical reactions involving radicals, most notably in antioxidant assay. Purple colored DPPH is reduced to yellow colored non-radical form in the presence of hydrogen donating antioxidants. Radical scavenging activity of the crude methanolic extract of actinomycetes broth from 20-100µg/ml was evaluated using DPPH radical scavenging assay. The results indicate that the crude methanolic extract exhibited the ability to reduce the DPPH radical in a concentration dependent manner with IC50 value of 38.3µg/ml, which indicates its antioxidant activity (fig. 3a).
Superoxide anion O2.−is particularly important, because it is by product in one-electron reduction of dioxygen O2, which occurs widely in nature. The superoxide anion radical is generated via several cellular oxidase systems. Superoxide also be involved in the ‘sensing’ of blood O2 levels by the carotid body. Hence, super oxide radical scavenging activity of the crude methanolic extract was explored. The IC50 value of the crude methanolic extract towards superoxide radical was 35µg/ml. The present results also show that the crude methanolic extract scavenging superoxide radicals in concentration dependent manner (fig. 3b).
The hydroxyl radical is short-lived, highly reactive and neutral form of hydroxide ion. Hydroxyl radicals are produced during decomposition of hydro peroxides by the reaction of excited atomic oxygen with water. It is an important radical formed in radiation chemistry, dissociation of H2O2 by UV-light and in Fenton reaction. Hydroxyl radicals can reduce disulfide bonds in proteins and causes unfolding and scrambled refolding into abnormal spatial configurations. As consequence, this reaction causes atherosclerosis, cancer and neurological disorders. Therefore, hydroxyl radical scavenging activity of the crude methanolic extract was investigated. The IC50 value of the crude methanolic extract towards hydroxyl is 30µg/ml. The results indicate strong hydroxyl radical scavenging capacity of the crude methanolic extract of marine actinomycetes (fig. 3c).

Fig. 3: Antioxidant activity of the crude methanolic extract of isolated marine Actinomycetes, DPPH radical (a), superoxide (b) and hydroxyl radical (c) scavenging activity of The crude methanolic extract at concentration ranging from 20-100µg/ml. (d) Ferric acid reducing ability of the crude methanolic extract at concentration ranging from 20-100µg/ml. (e) Different (radical scavenging activity of BHT at concentration ranging from 20-100µg/ml. The results were expressed as percent control. n=3, SE±0.01. *P<0.01 versus control
FRAP assay is a simple and novel method used for assessing total antioxidant power. It offers a putative index of antioxidant or reducing the potential of foods, beverages and nutritional supplements. It measures antioxidant activity of low molecular weight hydrophilic and hydrophobic compounds. The results of present study show that total antioxidant power of the crude extract of isolated actinomycetes increased with increasing concentration. The IC50 of the crude extract towards total antioxidant power is 46 AEAC/g dry weight. The results indicate the reducing ability of extract (fig. 3d and e).
Mohankumar and Kannabiran (2012) demonstrated the antioxidant potential of the actinomycetes isolated from the marine sediments collected from Puducherry coast, India [32]. Arulappan Jayaprakash Priya et al., (2012) evaluated antioxidant activity of actinomycetes isolated from marine soil sample collected near Puducherry coast, India [33]. Loganathan karthik et al., (2013) reported antioxidant activity of newly discovered lineage of marine actinobacteria from Nicobar marine sediments [34].
Antiproliferative activity
Drug discovery and development have established a respectable number of useful chemotherapeutic agents as well as a number of important successes in the treatment and management of human cancers. Nevertheless, the most common tumors are resistant to currently available drugs and the majority of them have limited activity against solid tumors [35]. However, search on anticancer compounds in biological extracts still has the great pharmacological importance.
Generally, antiproliferative activity of natural compounds was evaluated by enzyme, protein and DNA based assays. MTT assay is based on mitochondrial reductase enzyme routinely used for screening of the cytotoxic effect. In the present study, the cytotoxic effect of the crude methanolic extract of isolated actinomycetes at various concentrations was evaluated using MTT assay against MDA-MB 231 cells (fig. 4a). An extract is usually regarded as interesting for in vitro cytotoxic activity if IC50<100 μg/ml [36]. The the crude methanolic extract of isolated actinomycetes exhibited significantly high cytotoxic activity against MDA-MB 231 cells at 100 µg/ml with an IC50 value of 42.5μg/ml (p>0.01). Further, protein based Sulforhodamine B assay was used to evaluate the cytotoxic activity of the crude methanolic extract. The results show that percent of survival was decreased with increasing concentration with IC50 value of 35.8µg/ml, however standard anticancer drug, paclitaxel exhibited IC50 value 26.6 µg/ml against MDA-MB 231 triple negative breast cancer cells (fig. 4b).
In addition, effect of the crude methanolic extract on proliferation of MDA-MB 231 cells was evaluated by DNA based BrdU incorporation assay. The BrdU assay is a reliable in vitro non-radioactive method, which is very often used to quantify cell proliferation [37]. BrdU incorporation into DNA was measured in MDA-MB 231 cells treated with extract after 48 h exposure. The crude methanolic extract decreased BrdU incorporation in concentration dependent manner, when compared to untreated cells with the IC50value of 44.1µg/ml (fig. 4c).
In order to determine how the crude methanolic extract affects cell cycle progression, cells collected at 12, 24 and 48h following treatment with the crude methanolic extract at 44.1µg/ml, which is IC50 value of BrdU incorporation assay and subjected to flow cytometric analysis. Data revealed that in the cells treated with the crude methanolic extract for 24h, there was a significant transition from G1 to S phase. Quantitative analysis shows that S phase of the cell cycle was significantly increased from 12 to 24 h with an almost 5–8 fold increase in the cells after treatment with the crude methanolic extract. However, cells treated with the crude methanolic extract for 48h showed decrease in S phase cells (fig. 4d e and f). These results indicate that 48h treatment induced cell cycle arrest in MDA-MB 231 cells.

Fig. 4: Antiproliferative activity of the crude methanolic extract of isolated marine actinomycetes, (a) Cytotoxic activity of the crude methanolic extract as determined by MTT assay (20-100µg/ml). (b) Cytotoxic activity of the crude methanolic extract and paclitaxel as determined by SRB assay (20-100µg/ml). The results were expressed as percent control. (c) Effect of the crude methanolic extract on BrdU incorporation. The results were expressed as arbitrary units. Effect of the crude methanolic extract on G1 phase (d), S phase (e) and G2 M phase (f) of cells collected at 12, 24 and 48h. n=3, SE±0.01. *P<0.01 versus control
It is evident that cytotoxic compounds induce apoptosis by altering morphology. The observation of cell morphology under phase contrast microscope demonstrated that the crude methanolic extract (60μg/ml) significantly induced cell shrinkage, blebbing of the membrane and loss of cell adhesion in MDA-MB 231 cells (fig. 5a and b). These modifications are the characteristics of the apoptotic cells.

Fig. 5: Effect of The crude methanolic extract of isolated marine actinomycetes on morphology of MBA-MB 231 cells, overnight grown cells (104/well) were treated with the crude methanolic extract (a) and methanol control (b) for 48h and image was taken under phase contrast microscope. Cell shrinkage and blebbing indicates apoptosis at 20-100µg/ml treatment
Further, total antioxidant activity of the crude methanolic extract of isolated actinomycetes was correlated to the antiproliferative activity (fig. 6a and b). These experiments suggest that inhibition of cell proliferation in vitro by the the crude methanolic extract of isolated actinomycetes is explained by the antioxidant compounds.

Fig. 6: Correlation between total antioxidant activity and antiproliferative activityof the crude methanolic extract of isolated actinomycetes, (a) Correlation between total antioxidant activity and cytotoxicity activity. (b) Correlation between total antioxidant activity and BrdU incorporation. Statistical analysis and graphical exploration of the data were done using Pearson correlation coefficient calculator. Values are shown as means±SD of at least three independent experiments. Significance set as p<0.001
CONCLUSION
In conclusion, the results from in vitro experiments including DPPH, super oxide and hydroxyl radical scavenging, total antioxidant, cytotoxic and antiproliferative activity demonstrated that the crude methanolic extract of marine actinomycetes isolated from East Coast Bay of Bengal near Kakinada have the significant effect on antioxidant and antiproliferative activities. In addition, the antiproliferative activity was directly related to the antioxidant activity of the crude methanolic extract. The additive role of the crude methanolic extract may contribute the significantly to the potent antioxidant activity and the ability to inhibit cell proliferation in vitro. Hence, marine actinomycetes can be used as the potential source of natural antioxidants, as a food supplement or in the pharmaceutical and medical industries. Further, work should be performed to isolate and identify the antioxidative or antiproliferative components of the crude methanolic extract.
ACKNOWLEDGMENT
We acknowledge DST-SERB to partially support the anticancer activity. I would like to thanks GITAM University for providing me the lab facilities.
CONFLICT OF INTERESTS
The authors have declared no conflict of interest
REFERENCES
- Mallikarjuna Rao T, Ganga Rao B, Venkateswara Rao Y. Antioxidant activity of Spilanthes acmella extracts. Int J Phytopharmacol 2012;3:216-20.
- Wayner DDM, Burton GW, Ingold KU, Locke S. Quantitative measurement of the total, peroxyl radical-trapping antioxidant capability of human blood plasma by controlled peroxidation. FEBS Lett 1985;187:33-7.
- Arulpriya P, Lalitha P, Hemalatha S. In vitro antioxidant testing of the extracts of Samanea saman (Jacq). Merr Der Chem Sin 2010;1:73-9.
- Halliwell B, Gutteridge J. Oxygen toxicity, oxygen radicals, transition metals and disease. Biochem J 1984;219:1-14.
- Wee Sim Choo, Wee Khing Yong. Antioxidant properties of two species of Hylocereus fruits. Adv Appl Sci Res 2011;2:418-25.
- Dhivya Balakrishnan, Dhevendran Kandasamy, Paramasivam Nithyanand. A review on antioxidant activity of marine organisms. Int J ChemTech Res 2014;6:3431-6.
- Sithranga Boopathy N, Kathiresan K. Anticancer drugs from marine flora. J Oncol 2010. Doi.org/10.1155/2010/214186. [Article in Press]
- Sambamurthy K, Ellaiah P. A new streptomycete producing neomycin (B and C) complex S. marinensis (Part I). Hind Antibiot Bull 1974;17:24–8.
- Ellaiah P, Reddy APC. Isolation of actinomycetes from marine sediments of Visakhapatnam, east coast of India. Indian J Mar Sci 1987;16:134–5.
- Ellaiah P, Kalyan D, Rao VSV, Rao BVLN. Isolation and characterization of bioactive actinomycetes from sediments. Hind Antiobiot Bull 1996;38:48–52.
- Ellaiah P, Adinarayana K, Naveen Babu A, Thaer B, Srinivasulu T, Prabhakar T. Bioactive actinomycetes from marine sediments of bay of Bengal near machilipatnam. Geobios 2002;29:97–100.
- Ellaiah P, Ramana T, Bapi Raju KVVSN, Sujatha P, Uma Sankar A. Investigations on marine actinomycetes from bay of Bengal near Kakinada coast of Andhra Pradesh. Asian J Microbiol Biotechnol Environ Sci 2004;6:53–6.
- Gorajana A, Kurada BV, Peela S, Jangam P, Vinjamuri S, Poluri E, et al. 1-Hydroxy-1-norresistomycin, a new cytotoxic compound from a marine actinomycete,Streptomyces chibaensis AUBN1/7. A. J Antibiot 2005;58:526–9.
- Manivasagan P, Gnanam S, Sivakumar K, Thangaradjou T, Vijayalakshmi S, Balasubramanian T. Antimicrobial and cytotoxic activities of an Actinobacteria (Streptomyces Sp. PM-32) isolated from an offshore sediments of the bay of Bengal in Tamilnadu. Adv Biol Res 2009;3:231-6.
- Saha M, Jaisankar P, Das S, Sarkar KK, Roy S, Besra SE, et al. Production and purification of a bioactive substance inhibiting multiple drug resistant bacteria and human leukemia cells from a salt-tolerant marine actinobacteria sp isolated from the bay of Bengal. Biotechnol Lett 2006;28:1083-8.
- Suthindhiran K, Kannabiran K. Diversity and exploration of bioactive actinomycetes in the bay of Bengal of the puducherry cost of India. Indian J Microbiol 2010;50:76–82.
- Ravikumar S, Fredimoses M, Gnanadesigan M. Anticancer property of sediment actinomycetes against MCF-7 and MDA-MB-231 cell lines. Asian Pac J Trop Biomed 2012;2:92-6.
- Salle AJ. Laboratory manual on fundamental principles of Bacteriology. 3rd Edn; 1939. p. 175.
- Williams ST, Coss T. Actinomycetes isolation from soil. In: Methods in Microbio. Booth C. Ed. Academic Press: London, New York; 1971. p. 295-334.
Lampert Y, Kelman D, Dubinsky Z, Nitzan Y, Hill RT. Diversity of culturable bacteria in the mucus of the red sea coral Fungia scutaria. FEMS Microbiol Ecol 2006;58:99-108.
Rama Rao M, Bhaskar Reddy I, Raja Gopal SV, Naveen Kumar AD, Ramesh A, Kartika T. Effect of Holoptelea intigrifolia bark extract on radical scavenging and 5’-lipoxygease activities. Biomed Pharmacol J 2008;1:349-58.
Kumari S, Malla RR, Reddy IB, Rao VR. Study on radical scavenging activity and analysis of bioactive compounds in selected Indian medicinal plants. Biosci Biotech Res Asia 2010;72:913-8.
- Liu F, Ooi VEC, Chang ST. Free radical scavenging activity of mushroom polysaccharide extracts. Life Sci 1997;60:763-71.
- Benzie IFF, Strain JJ. The ferric reducing ability of plasma (FRAP) as a measure of “antioxidant power”. The FRAP assay. Anal Biochem 1996;239:70-6.
- Rana Abu-Dahab, Fatma Afifi, Violet Kasabri, Lara Majdalawi, Randa Naffa. Comparison of the antiproliferative activity of the crude ethanol extracts of nine salvia species grown in Jordan against breast cancer cell line models. Pharmacogn Mag 2012;8:319–24.
- R Rao Malla, Raghu H, Rao JS. Regulation of NADPH oxidase (Nox2) by lipid rafts in breast carcinoma cells. Int J Oncol 2010;37:1483-93.
- Sirisha B, Haritha R, Jagan Mohan YSYV, Siva Kumar. K, Ramana T. Bioactive compounds from marine Actinomycetes isolated from the sediments of bay of Bengal. Int J Pharm Chem Biol Sci 2013;3:257-64.
- Mincer TJ, Jensen PR, Kauffman CA, Fenical W. Widespread and persistent populations of a major new marine actinomycete taxon in ocean sediments. Appl Environ Microbiol 2002; 68:5005–11.
- Laidi, Rabah-Forar, Amany Kansoh, Ali L, Elshafei, Bengraa Cheikh M. Taxonomy, identification and biological activities of a novel isolate of Streptomyces tendae. Arab J Biotechnol 2006;9:427-36.
- Sivakumar K, Sahu MK, Thangaradjou T, Kannan L. Research on marine actinobacteria in India. Indian J Microbiol 2007;47:186-96.
- Ganesh Babu B, Naveen Kumar AD, Bhaskar Rao D, Laxmi koteswaramma K, Swarna P, Malla RR. Analysis of antioxidant and anticancer potentials of Urginea indica, an endangered medicinal plant. J Pharm Res 2012;5:4921-8.
- Mohankumar Thenmozhi, Krishnan Kannabiran. Antimicrobial and antioxidant properties of marine actinomycetes Streptomyces sp VITSTK7. Oxidants Antioxidants Med Sci 2012;1:51-7.
- Arulappan Jayaprakash Priya, Elumalai Sagadevan, Perumal Dhanalakshmi, Sivaji Sathish Kumar, Vijayan Karthikeyan, Perumal Arumugam. Detection of antioxidant and antimicrobial activities in marine Actinomycetes isolated from puducherry coastal region. J Modern Biotechnol 2012;1:63–9.
- Loganathan karthik, Gaurav kumar, Kokati Venkata Bhaskar Rao. Antioxidant activity of newly discovered lineage of marine actinobacteria. Asian Pacific J Trop Med 2013;16:325-32.
- Vandana Srivastava, Arvind Singh Negi, Kumar JK, Gupta MM, Suman Khanuja PS. Plant-based anticancer molecules. A chemical and biological profile of some important leads. Bioorg Med Chem 2005;13:5892–908.
- Boyd MR. The NCI in vitro anticancer drug discovery screen: concept, implementation, and operation. In: Anticancer Drug Development Guide: Preclinical Screening, Clinical Trials, and Approval. Ed. Teicher BA. Humana Press: Totowa, NJ; 1997. p. 23-42.
- Ferreira PMP, Santos AG, Tininis A, Costa PM, Cavalheiro AJ, Bolzani VS, et al. Casearin X exhibits cytotoxic effects in leukemia cell striggered by apoptosis. Chem Biol Interact 2010;188:497–504.
How to cite this article
- Nagaseshu P, Gayatridevi V, Anil Kumar B, Seema Kumari, Murali Mohan G, Rama Rao Malla. Antioxidant and antiproliferative potentials of marine Actinomycetes. Int J Pharm Pharm Sci 2016;8(8):277-284.